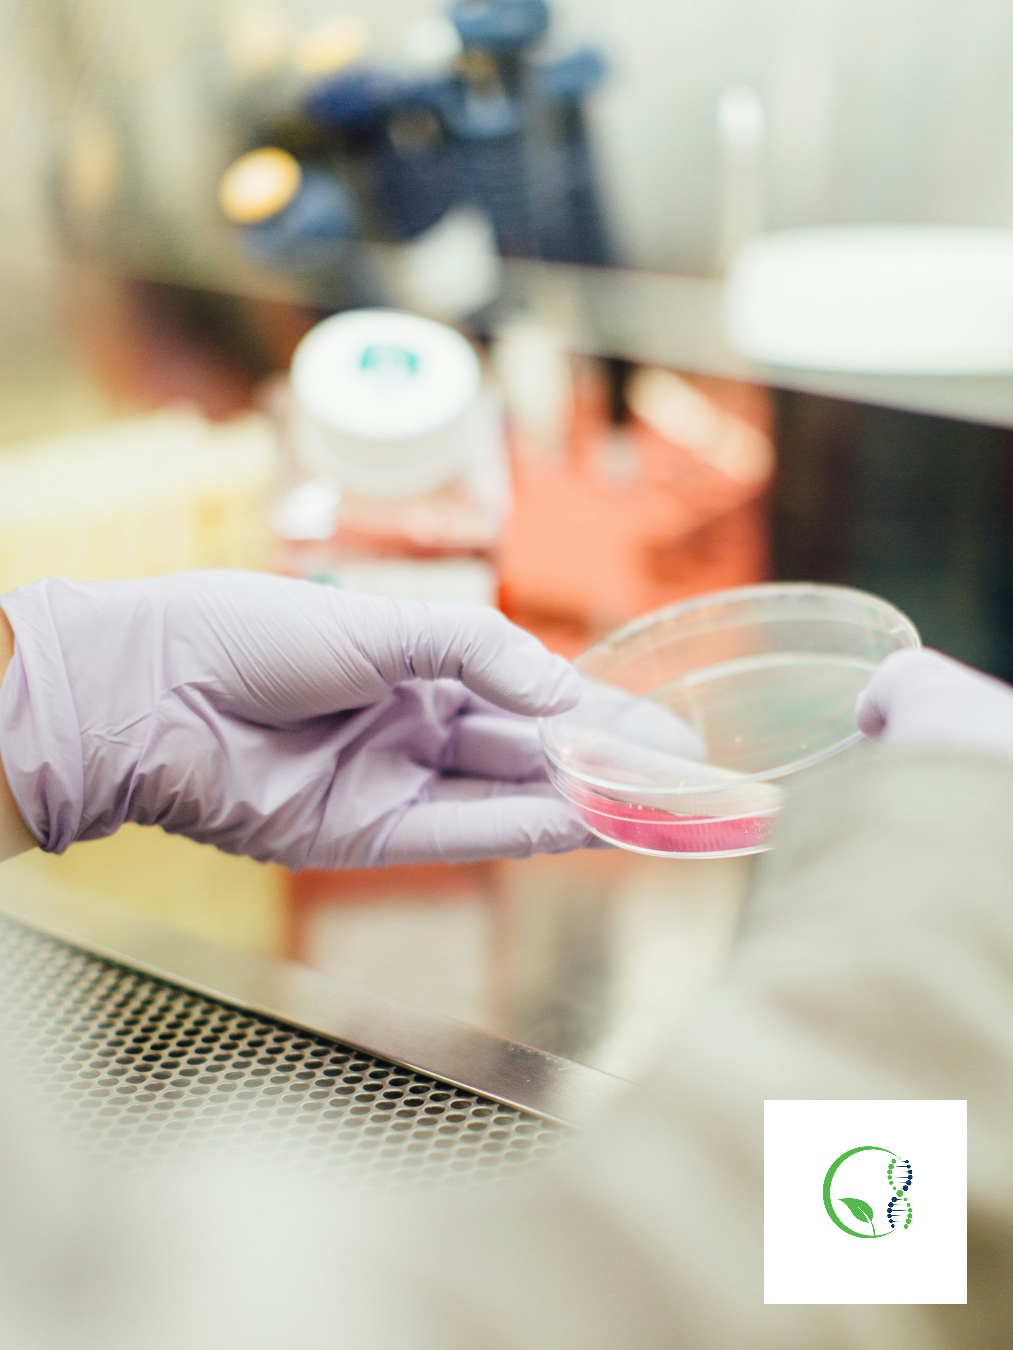
The Benefits of Stem Cell Therapy: How Regenerative Medicine Is Changing Modern Healthcare

Executive Health Optimization Through Regenerative Therapy: A Strategic Approach to Performance, Longevity, and Biological Resilience
Discover how regenerative medicine and stem cell therapy support executive performance, recovery, and long-term vitality.
What Conditions Can Stem Cell Therapy Treat? A Comprehensive Look at Regenerative Medicine Applications
Discover the conditions stem cell therapy may help support, from arthritis and joint pain to inflammation and longevity medicine.
Stem Cell Therapy for Anti-Aging: Can Regenerative Medicine Support Healthy Aging?
Explore how stem cell therapy for anti-aging and longevity may support cellular health, vitality, and regenerative wellness.
Stem Cell Therapy for Arthritis: A Regenerative Approach to Joint Pain Relief
Discover how stem cell therapy for arthritis may help reduce inflammation, support cartilage repair, and provide a minimally invasive alternative to surgery.
Stem Cell Therapy: Benefits, Safety, and What to Expect from Regenerative Medicine
Learn how stem cell therapy works, its potential benefits, safety considerations, and FAQs about regenerative medicine treatment options.
The Benefits of Stem Cell Therapy: How Regenerative Medicine Is Changing Modern Healthcare
Discover the benefits of stem cell therapy and how regenerative medicine may support healing, reduce inflammation, and improve quality of life.